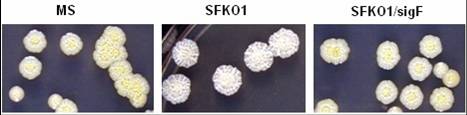

|
|
TUBERCULOSIS
and MICROBIAL INFECTION
|
 |
|
Microbial
infection research in CDRI focus on Tuberculosis,
Fungal and Viral infection |
|
|
|
Tuberculosis
continues to kill millions of people worldwide
(WHO Global Report, 2006) despite the disease
is curable with a highly effective drug
regimen in the market. The failure of the
present therapy stems largely from the lengthy
course of the drugs-in-combination leading
to poor compliance of the drugs. This allows
the emergence of multi drug resistance (MDR)-TB,
the most urgent problem at present. Therefore,
simplifying and shortening treatment
for drug-sensitive tuberculosis and providing
new treatments for MDR-TB constitute two
major goals in the development of novel
drugs for Tuberculosis. TB
research and drug screening program at CDRI
focus towards this end. Our team comprises
biologists, chemists and pharmaceuticist
who work synergistically in the different
areas of TB drug development research. |
|
| |
|
| BASIC
RESEARCH |
| |
Mycobacterial
pathogenesis, host-pathogen interaction
and latency. |
| |
Regulation
of key metabolic pathways, interaction
between host-pathogen kinases. |
| |
Generation
of sigma factors knock outs and characterizing
their regulon |
|
M. smegmatis mc2155 ΔsigF
mutant (SFKO1) lacks pigment unlike
its wild type (MS) and complemented
(SFKO1/sigF) counterpart.
|
|
Elucidation of structure
of Mycobacterium tuberculosis
proteins through X-ray diffraction
and NMR spectroscopy. |
|
Studies on membrane-associated
peptides and proteins. |
|
| |
|
| Drug
Design and Synthesis |
| |
| |
Anti-tubercular
compounds based on rational approaches
of drug design including CADD &
virtual screening. |
| |
Trisubstituted Methane
Derivatives as anti-tubercular agents.
Synthesis of constrained analogues
of diarylquinoline, R207910.
|
|
Structure based virtual
screening and 3D-QSAR based development
of computational predictive models for
the design of novel anti-tubercular
agents. |
|
Anti-tubercular agents
based on sugar analogues, and natural
products. |
|
Design of biologically
active novel peptides/peptidomimetics.
|
|
| |
| Screening
and drug development |
| |
In
vitro, in vivo, macrophage
based and high throughput screening.
Lux-based assay system and BACTEC
in use for screening of anti-TB compounds.
|
| |
Screening against selected
targets and drug resistant non-pathogenic
strain. |
|
Studies of PK/PD of
anti-mycobacterial compounds. |
|
The quality control
and formulation development of anti-tubercular
& antimicrobial candidates for
drug development. |
|
Preparation and characterization
of pulmonary delivery systems containing
the anti-tubercular agents. |
|
| |
| Significant
achievements |
| |
Development
of PCR based TB diagnosis kit. |
| |
Generation
of a recombinant non-pathogenic mycobacterial
strain for target
based screening (against FAS-II elongation
pathway).
A recombinant M. aurum strain
carrying H37Rv kas operon
promoter fused to
β gal gene selectively
upregulates the synthesis of reporter
gene upon treatment with FASII inhibitors.
|
 |
|
Development
of murine infection model for persistence
and reactivation. |
|
Resolved
the structure of adenylation domain
of Mycobacterium tuberculosis
NAD+ dependent DNA ligase –
a potential molecule for novel drug.
LigA is an ~70 kD multi-domain enzyme
which seals nicks in dsDNA. The enzyme
is recognized as a novel target as
it is found exclusively in bacteria
and some viral sources. |
|

Schematic of the MtuLigA
adenylation domain crystal structure.
Individual subdomains 1a and 1b are
shown in dark blue and cyan,
respectively. Srivastava SK, Tripathi
RP, Ravishankar Ramachandran
J. Biol. Chem.
(2007) |
|
The first
solution structure of Mycobacterium
tuberculosis Pth protein (MtPth)
using NMR- enables
designing of novel inhibitors. |
|
Three target
based screen systems for the screening
of antimycobacterial drugs –
against FASII elongation pathway, M.tb
kinases (PknK and PknG) and M.tb
DNA ligase. |
|
Developed
nano-sized delivery system of CDRI anti-TB
molecules. |
|
| |
| RECENT
PUBLICATIONS |
| |
Srivastava
SK, Dube D, Vandna, K, Jha AK, Hajela
K & Ravishankar Ramachandran.
NAD+-dependent DNA ligase (Rv3014c)
from M. tuberculosis: Novel
structure-function relationship and
identification of a specific inhibitor.
PROTEINS(2007):
69, 97-111. |
| |
Neeta Gupta
and Bhupendra N Singh. Deciphering
kas operon locus in Mycobacterium
aurum and genesis of a recombinant
strain for rational based drug screening.
Journal of Applied Microbiology
(2008): 105,
1703-1710. |
| |
Anirudh
Kumar Singh and Bhupendra
N. Singh. Differential
expression of sigH paralogs
during growth and different stress
conditions in Mycobacterium smegmatis.
Journal of Bacteriology
(2009): 191(8), 2888-93. |
|
Srivastava
SK, Tripathi RP, Ravishankar
Ramachandran. NAD+ -dependent
DNA ligase (rv3014c) from M. tuberculosis:
Crystal structure of the adenylation
domain and identification of novel
inhibitors. J. Biol. Chem.
(2007) 280, 30273-30281. |
|
Luthra A, Mahmood,
A, Arora A and Ravishankar
Ramachandran. Characterization
of Rv3868: an essential hypothetical
protein of the ESX-1 secretion system
in M. tuberculosis J.
Biol. Chem. (2008):
283, 36532-41. |
|
Chaurasiya SK and Srivastava
KK. Differential regulation
of protein kinase C isoforms of macrophages
by pathogenic and non-pathogenic mycobacteria.
Mol. and Cell. Biochemistry
(2008): 318, 167-174. |
|
Verma RK, Kaur J, Kumar
K, Yadav AB, Misra A.
Intracellular time course, pharmacokinetics,
and biodistribution of isoniazid and
rifabutin following pulmonary delivery
of inhalable microparticles to mice.
Ant. Agt.
Chem. (2008): 52(9),
3195-201. |
|
V Chaturvedi, N Dwivedi,
RP Tripathi and Sinha S.
Identification and evaluation of Mycobacterium
smegmatis as a possible surrogate
screen for selecting molecules active
against multi-drug resistant M.
tuberculosis. J. Gen
& App Micro (2007):
53, 333-337. |
|
Pulavarti SV, Jain
A, Pathak PP, Mahmood A, Arora
A. Solution structure and
dynamics of peptidyl-tRNAhydrolase
from M. tuberculosis H37Rv.
J Mol Biol. (2008):
18;378(1), 165-77. |
|
Singh N, Pandey J,
Yadav A, Chaturvedi V, Bhatnagar S,
Gaikwad AN, Sinha SK, Kumar A, Shukla
PK, Tripathi RP.
A facile synthesis of alpha,alpha'-(EE)-bis(benzylidene)-cycloalkanones
and their antitubercular evaluations.
Eur J Med Chem. (2009):
44(4), 1705-9. |
|
V. Srivastava, C. Rouanet,
Ranjana Srivastava,
B. Ramalingam, C. Locht and B.S. Srivastava.
Macrophage specific M. tuberculosis
genes identified by green fluorescent
protein and kanamycin resistance selection.
Microbiology (2007):
153,659-66. |
|
| |
| TEAM
MEMBERS |
| |
| |
|
|
Fungal
Infection:
In vitro and in vivo evaluation of antifungal
and antibacterial compounds/extracts and
development of monoclonal antibodies for
therapy and diagnosis -
Dr. P K Shukla.
Viral Infection:
In vitro screening of anti-HIV (anti-RT)
compounds and in vivo (mice) screening model
for anti-Dengue virus compounds -
Dr.
R K Tripathi. |
|
|
|
|
website
copyright © Central Drug Research Institute.
All rights reserved.
No part of this should be Downloaded or used
in any way other than the non-commercial purposes
without prior permission of the Director,
CDRI. |
|
|
|
|
|